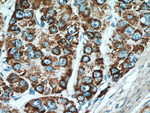
MEK4 Antibody in Immunohistochemistry (Paraffin) (IHC (P))

Search
Proteintech
MEK4 Polyclonal Antibody
{{$productOrderCtrl.translations['antibody.pdp.commerceCard.promotion.promotions']}}
{{$productOrderCtrl.translations['antibody.pdp.commerceCard.promotion.viewpromo']}}
{{$productOrderCtrl.translations['antibody.pdp.commerceCard.promotion.promocode']}}: {{promo.promoCode}} {{promo.promoTitle}} {{promo.promoDescription}}. {{$productOrderCtrl.translations['antibody.pdp.commerceCard.promotion.learnmore']}}
产品信息
17340-1-AP
种属反应
已发表种属
宿主/亚型
分类
类型
抗原
偶联物
形式
浓度
规格
纯化类型
保存液
内含物
保存条件
运输条件
产品详细信息
Immunogen sequence: NPPFKSTAR FTLNPNPTGV QNPHIERLRT HSIESSGKLK ISPEQHWDFT AEDLKDLGEI GRGAYGSVNK MVHKPSGQIM AVKRIRSTVD EKEQKQLLMD LDVVMRSSDC PYIVQFYGAL FREGDCWICM ELMSTSFDKF YKYVYSVLDD VIPEEILGKI TLATVKALNH LKENLKIIHR DIKPSNILLD RSGNIKLCDF GISGQLVDSI AKTRDAGCRP YMAPERIDPS ASRQGYDVRS DVWSLGITLY ELATGRFPYP KWNSVFDQLT QVVKGDPPQL SNSEEREFSP SFINFVNLCL TKDESKRPKY KELLKHPFIL MYEERAVEVA CYVCKILDQM PATPSSPMYV D (50-399 aa encoded by BC036032)
靶标信息
MAP2K4 (MEK4) serine/threonine kinase (mitogen-activated protein kinase 4) MEK4 or MKK4 is a dual specificity kinase of the STE7 family that phosphorylates and activates JNK1 and -2 as well as p38. MAP2K4 preferentially phosphorylates the tyrosine residue of JNKs. MAP2K4 mediates a variety of physiological and pathophysiological processes such as responses to cellular stresses and inflammatory cytokines. MAP2K4 is important for carcinogenesis; a loss-off-function mutation in MAP2K4 was found in lung and pancreatic tumors. Conversely, a pro-oncogenic role was also found for MAP2K4.
仅用于科研。不用于诊断过程。未经明确授权不得转售。
生物信息学
蛋白别名: C-JUN N-terminal kinase kinase 1; c-Jun NH2-terminal kinase kinase 1; Dual specificity mitogen-activated protein kinase kinase 4; JNK kinase 1; JNK-activated kinase 1; JNK-activating kinase 1; JNKK; JNKK 1; MAP kinase kinase 4; MAP2K4; MAPK/ERK kinase 4; MAPKK 4; MEK 4; mitogen activated protein kinase kinase 4, variant 1; SAPK kinase 1; SAPK/ERK kinase 1; SAPK/Erk/kinase 1; SEK1; Stress-activated protein kinase kinase 1; unnamed protein product
基因别名: JNKK; JNKK1; MAP2K4; MAPKK4; MEK4; MKK4; PRKMK4; SAPKK-1; SAPKK1; SEK1; SERK1; SKK1
UniProt ID: (Human) P45985, (Mouse) P47809
Entrez Gene ID: (Human) 6416, (Mouse) 26398